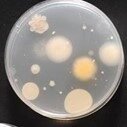
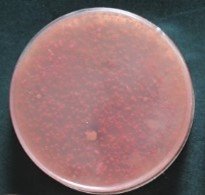
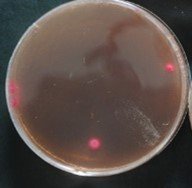

プライムデルタ デオドラント~実験の結果まとめ
① 消臭試験結果 ~臭い標準液-生ゴミ臭、キムチ臭、たばこ臭を指標として~
| 標準液の種類 | デオドラント噴霧、2分後 | デオドラント噴霧、30分後 | ||
| 標準液の残香 | 精油の香り | 標準液の残香 | 精油の香り | |
| 強い生ゴミ臭 | 無し | 微香有り | 無し | 微香有り |
| 強いキムチ臭 | 無し | 微香有り | 無し | 微香有り |
| たばこ臭 | 無し | 微香有り | 無し | 微香有り |
| 強いたばこ臭 | 弱いたばこ臭 | 微香有り | 弱いたばこ臭 | 微香有り |
②プライムデルタデオドラントの除菌試験
1最近試験の実施方法
一般細菌および大腸菌群培養液 1ml中に除菌剤、塩化ベンザルコニウム(オスバン液)を適量加えたプライムデルタデオドラント溶液1mlを添加し、1分間放置後シャーレに塗布し、37℃で一晩培養した。
2 実験結果
-:コロニーが認められない
1+:数個のコロニーが認められる
2+:1+よりも多くコロニーが認められる
3+:中程度にコロニーが認められる
4+:比較的多くのコロニーが認められる
5+:多くコロニーが認められる
| 塩化ベンザルコニウム(%) | 一般細菌 | 大腸菌群 | |
| (+)コントロール | (ー) | 5+ | 5+ |
| (-)コントロール(培地のみ) | ブランク | - | - |
| プライムデルタデオドラント | ① 0.01 | - | - |
| プライムデルタデオドラント | ② 0.016 | - | - |
| プライムデルタデオドラント | ③ 0.025 | - | - |
一般細菌
説明文
大腸菌群
説明文
④ ホルマリン消臭試験 その①
真空法ガス採取器及びエア-サンプラを用いたホルマリン量測定

上記拡大写真

噴霧後

デオドラント噴霧後
ホルマリン消臭試験その②
ホルマリン液を噴霧した容器中にPDデオドラントをスプレ-し、その前後で赤外線分析を行った。PDデオドラント噴霧により、ホルマリン液のピ-クがほとんど消失した。